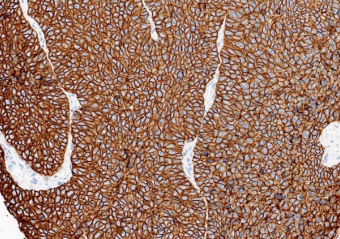

TOP2A Antibody (DA113)
TOP2A Antibody (DA113)
Recombinant monoclonal rabbit antibody
Description
DNA Topoisomerase II alpha (Topo IIa) is a nucleic enzyme that affects the topological structure of DNA by interacting with the double-helix DNA, thus playing an important role in DNA replication, transcription, recombination, condensation, and segregation. Type II topoisomerases cut both strands of the DNA helix simultaneously in order to change the linking number of the molecule. Topo IIa is essential in the separation of daughter strands at the end of replication. Failure to separate these strands leads to cell death. In cancers, the Topo IIa is highly expressed in highly-proliferating cells.
Topo IIa has been identified by DNA microarray and transcriptional profiling as a gene that is overexpressed in Cervical Carcinomas. The TOP2A gene is approximately 30 kb in size and encodes a 170 kDa protein. Topo IIa protein is expressed in proliferating cells and in numerous human malignant tumors, including colon, gastric and breast cancers, Lymphomas and others. In certain cancers, such as Peripheral Nerve Sheath Tumors, high expression of this protein is also associated with poor patient survival. Type II topoisomerases are the targets for anticancer drugs, such as topoisomerase II inhibitor therapies like the anthracyclines (Doxorubicin and Epirubicin). 1-6
References
2. Chen Y, et al. Cancer Res. 2003;63:1927-1935
3. Heck MMS, Earnshaw WC, J Cell Biol. 1986;103:2569-2581
4. Jørgensen JT, et al. Oncologist. 2007;12:397-405
5. Santin AD, et al. Virology. 2005;331:269-291
6. U.S. Department of Health and Human Services: Centers for Disease Control and Prevention. Guidelines for Safe Work Practices in Human and Animal Medical Diagnostic Laboratories. Supplement / Vol. 61, January 6, 2012.
Specifications
Order information
| RMA1A032 | Concentrate | IVD(R) |
| RMA1A032 | 10 ml Ready to use | IVD(R) |
| RMA1A032 | 6 ml Ready to use | IVD(R) |
| RMA1A032 | 3 ml Ready to use | IVD(R) |


